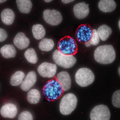
May Journal Cover

Journal Archive
Current Issue
ABOUT THIS IMAGE
A Germinated Microsporidian Spore in Close Proximity to the Host Cell Surface
Transmission electron micrograph shows a germinated microsporidian spore adjacent to a host cell, with a polar tube extending to transfer sporoplasm into the host cytoplasm. The study identified EnP1, a nucleus-targeted effector secreted by microsporidia, which enhances their proliferation by interacting with host histone H2A and inhibiting ferroptosis. This research highlights how microsporidia alter host cell functions through secreted effector proteins, ultimately facilitating their own survival and contributing to disease progression. Guan et al. 2026
Image Credit: Bing Han